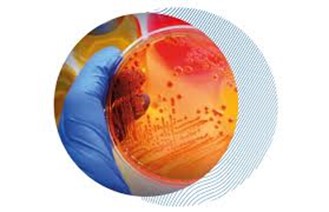

The primary objectives of this subject are to provide a comprehensive understanding of the various techniques used for controlling microbial activities. This includes methods for microbiological examination of samples and biological fluids, quality control measures. Students will learn to assess and manage microbial growth effectively, ensuring the safety and quality of products.
- Enseignant: Ahmed BOULAL

Molecular Biology and Genetic Engineering explores how genetic information is stored, expressed, and regulated at the molecular level. It focuses on DNA replication, transcription, translation, and gene regulation. The course also covers modern genetic manipulation techniques — such as cloning, PCR, recombinant DNA, and CRISPR — used in research, medicine, agriculture, and biotechnology.
- Enseignant: sarra henouda

- Enseignant: أحمد حيرش